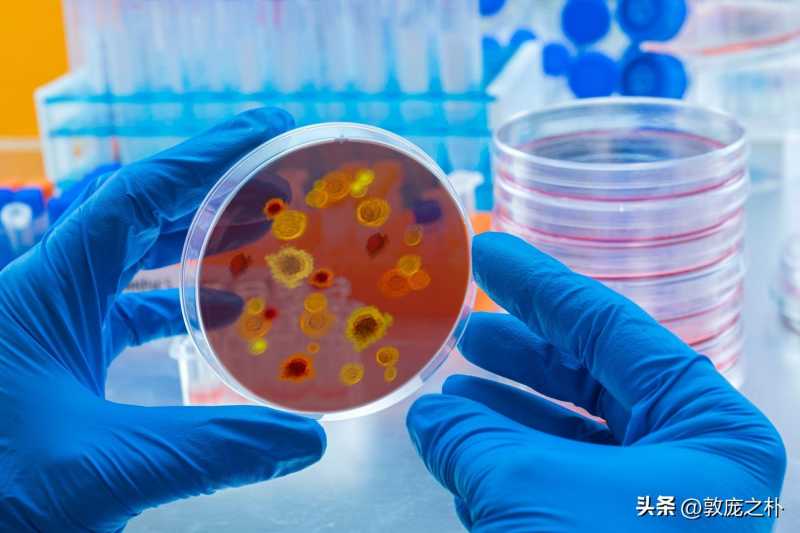

地球上12种最致命的病毒
自从我们的物种进化成现代形式之前,人类就在与病毒作斗争。对于某些病毒性疾病,疫苗和抗病毒药物使我们能够防止感染并阻止广泛传播,帮助患者康复。但是,要赢得对抗病毒的斗争,我们还有很长的路要走。
在最近的几十年中,几种病毒已经从动物传播到人类,并引发了大规模的疫情爆发,夺去了数千人的生命。曾在2014-2016年爆发的西非埃博拉病毒疫情感染者达90%,使其成为埃博拉家族中最致命的病毒成员。
但是,还有其他一些病毒同样致命、甚至更毒。包括目前正在全球范围内爆发的新型冠状病毒,尽管死亡率较低,但由于我们尚无与之对抗的手段,因此仍然对公共健康构成严重威胁。
生物安全等级
生物安全是人类生物危害(Biohazard)的定义为生物性的传染媒介通过直接感染或间接破坏环境而导致对人类、动物或者植物的真实或者潜在的危险。
世界通用生物安全水平标准是由美国疾病控制中心(CDC)和美国国家卫生研究院(NIH)建立的。根据操作不同危险度等级微生物所需的实验室设计特点、建筑构造、防护设施、仪器、操作以及操作程序,实验室的生物安全水平可以分为基础实验室-一级生物安全水平、基础实验室-二级生物安全水平、防护实验室-三级生物安全水平和最高防护实验室-四级生物安全水平(也是安全防护要求最高的等级)。
病毒的生物安全等级可分为四个级别(BSL-1~BSL-4):
一级BSL-1:麻疹病毒、腮腺炎病毒等。
进行试验研究用的物质都是已知的所有特性都已清楚并且已证明不会导致疾病的多种微生物物质。研究通过日常的程序在公开的实验台面上进行。不需要有特殊需求的安全保护措施。操作人员只需经过基本的实验室实验程序培训并且通常由科研人员指导,在这样的环境下并不需要生物安全柜的存在。
生物安全柜国际标准的规定可分为一级、二级和三级三大类以满足不同的生物研究和防疫要求。安全柜的分类级别与生物安全等级无关。生物安全柜可保护工作人员和环境而不保护样品。
二级BSL-2:流感病毒等。
进行试验研究用的物质是一些已知的中等程度危险性的并且与人类某些常见疾病相关的物质。操作者必须经过相关研究的操作培训并且由专业科研人员指导。对于易于污染的物质或者可能产生污染的情况进行预先的处理准备。一些可能涉及或者产生有害生物物质的操作过程都应该在生物安全柜内进行,在这些条件下最好使用二级的生物安全柜。
二级生物安全柜是目前应用最为广泛的柜型。按照NSF49的中的规定,二级生物安全柜依照入口气流风速、排气方式和循环方式可分为4个级别:A1型,A2型(原B3型),B1型和B2型。所有的二级生物安全柜都可提供工作人员、环境和产品的保护。
三级BSL-3:SARS病毒、炭疽芽孢杆菌、鼠疫杆菌、结核分枝杆菌、狂犬病毒等。
使人们致病或者有生命危险可能的物质。我们需要保护一切在周围环境中等操作者免于暴露于这些有潜在危险的物质中。通常使用二级或者三级的生物安全柜是必需的。
四级BSL-4:埃博拉病毒、马尔堡病毒、拉萨热等。
进行试验研究的物质是一些极高危险性并且可以致命的有毒物质,可以通过空气传播并且现今并没有有效的疫苗或者治疗方法来处理。操作者必须经过熟练的关于进行这种极高危险性物质研究的培训,并且应该很熟悉一些相关操作,保护设施,实验室设计等等方面对于这些极高危险性物质的预防。同时也必须由在此研究领域非常有经验的科研人员进行指导,严禁独自在4级实验室工作。
对于实验室的进出应当严格的进行控制,实验室一定要单独的建造或者建造在一栋大楼中于其他任何地方都分离开的独立房间内,并且要求有详细的关于研究的操作手册进行参考。在这样的实验研究中三级的生物安全柜是必需的。
三级生物安全柜是为3-4级实验室生物安全等级而设计的,柜体完全气密,工作人员通过连接在柜体的手套进行操作,俗称手套箱(Glove box),试验品通过双门的传递箱进出安全柜以确保不受污染,适用于高风险的生物试验。

以下是12个最凶残的病毒杀手,它们的厉害之处在于个体感染后(尤其是患基础病的人群)死亡风险陡增,感染人数之多构成越来越大的威胁。
1.新型冠状病毒(COVID-19)

SARS-CoV-2与SARS-CoV属于同一病毒大家族,称为冠状病毒,在感染人之前先通过中间动物传播。截止目前,该病毒已经感染了全世界各地成千上万的人。
免疫系统是人体抵抗感染和疾病的第一道防线。健康的免疫系统可以识别病原体,并将其与人体细胞区分开。但是,营养不良和生活方式的选择导致的免疫系统较弱,会使身体容易感染,例如冠状病毒……
有医师就指出,这个病毒的特性,不仅狡猾还专治“各种不服”。
由于新型冠状病毒是属于信息核糖核甘酸(mRNA),代表这病毒的遗传物质结构是单链,比其他病毒脆弱,也就更容易产生变异。另外病毒表面有亲和ACE2的蛋白质凸起,也就是说人体内有相同成分,人体一开始遇到新冠病毒,会把它当成身体一部分而不抵抗,这两点就是病毒狡猾的地方。

在潜伏期,病毒开始在体内繁殖,这时人不具有传播性,病毒也不会攻击人体,但免疫系统也不会杀死病毒。直到病毒在体内繁殖越来越多,开始占领口腔、肠胃、血液到最后整个人都是病毒,连咳嗽、打喷嚏都有无数病毒飞出来,都还只是和病毒共存的时间,病毒本身还不具有破坏性。
等到人体免疫系统彻底被病毒挤兑时,才开始杀毒,从发烧开始清理病毒,尽管身体感觉清理得差不多了,就会停止,但不会全部杀光。只要不威胁免疫系统时,病毒就没事,而此时透过检测也测不出来。
可隔没多久,病毒又开始偷偷复制发育,所以就会出现有可能 “已治好的”人回家了,过不了20天又会“复阳”。
面对病毒的这种习性,医生无奈指出,“病毒没有国界,病毒不分你我。除非是等有效疫苗研发出来,否则我们就是要乖乖的......戴口罩、勤洗手、保持社交距离”。如果您觉得不服气,到处走、不戴口罩、不遵循隔离…那这个病毒就专治您这种不服。所以,尊重自己也是尊重他人的生命,请在病毒面前保持“敬畏”。
防疫是每个人的责任。最好的方式,要让民众清楚这个疾病的重症风险为何,但同时也要知道,每个人都可能成为传播疫病的源头。
同时,多项研究也提出警告,无症状感染族群的病毒传播力,其实并不亚于出现症状的确诊病患。要如何找出无症状感染者?防疫专家说,大规模的病毒检测,是直接有效的对策。
2.冠状病毒(MERS-CoV)
导致中东呼吸综合征(MERS)的病毒2012年在沙特阿拉伯爆发,2015年在韩国爆发。MERS病毒与SARS-CoV和SARS-CoV-2属于同源病毒家族,也可能起源于蝙蝠。该疾病在进入人类之前曾被骆驼感染,并在受感染的人体内引发咳嗽、发烧和呼吸急促。
MERS通常会发展为严重的肺炎,估计死亡率在30%至40%之间,使其成为已知的从动物到人的冠状病毒中最具致死性的病毒。与SARS-CoV和SARS-CoV-2一样,MERS也没有经过批准的治疗方法或疫苗。
3.马尔堡病毒(Marburg virus)

科学家在1967年发现了马尔堡病毒,当时德国的实验室人员中有小规模的爆发,感染与从乌干达进口的猴子中。马尔堡病毒与埃博拉病毒相似,两者都可引起出血热,这意味着被感染的人在全身发高烧和出血,并导致休克、器官衰竭和死亡。
根据世界卫生组织(WHO)的数据,首次爆发的死亡率为25%,但在1998-2000年的刚果民主共和国爆发以及2005年的安哥拉爆发中,死亡率均超过80%。
Nature Communications杂志发表的一篇论文首次证实马尔堡病毒的自然宿主为埃及果蝠,马尔堡病毒是埃博拉病毒的近亲。
4.埃博拉病毒(Ebola virus)

埃博拉病毒的生物风险等级为4级,最高。
埃博拉第一次出现是在1976年非洲埃博拉河流域。当时苏丹南部和刚果(金)的埃博拉河地区爆发了人类已知的第一例埃博拉疫情,此后的40多年里,非洲共发生了十起大大小小的埃博拉疫情。刚果茂密的热带森林是埃博拉病毒的天然病毒库。

40多年以来,埃博拉病毒神出鬼没,每一次出现都导致巨大的恐慌和人员死亡,然后,病毒消失的无影无踪,只待下一次爆发。
埃博拉病毒是通过接触血液或其他体液或感染者或动物的组织传播的。这个病毒至今查不到源头,不知道它从哪来,仿佛从天而降。
埃博拉病毒进入体内,第一个目标就是免疫系统。它将免疫细胞变成自己的傀儡,利用它生产病毒,运送到身体各个部位。一旦被侵入,免疫系统基本就崩溃了。紧接着,血管堵塞、凝血功能丧失,直至病毒让患者的内脏支离破碎...最常见的就是皮下出血和内出血。

对于这个病毒目前还没有完全有效的治疗方式,而且它还在一直进化,拥有很多种变体,一代比一代难对付。埃博拉传染能力极强(致死率90%),只要有一个病例,就可能导致疫情的再次爆发。
据世卫组织称,西非疫情始于2014年初,是迄今为止该病最大,最复杂的疫情。

5.狂犬病(Rabies)

尽管1920年代开始使用的狂犬病疫苗已使这种疾病在发达国家极为罕见,但这种情况在印度和非洲部分地区仍然是一个严重的问题。Muhlberger说:“它破坏人的大脑,这是一种非常非常糟糕的疾病。”尽管有抗狂犬病的疫苗,但如果不接受治疗,就有100%可能死亡的可能性。”
6.艾滋病毒(HIV)

在现代世界中,最致命的病毒可能是艾滋病毒。“它仍然是最大的杀手,”美国传染病学会及其发言人Amesh Adalja博士说。自1980年代初首次发现艾滋病毒以来,估计已有3200万人死于艾滋病。Adalja博士说:“目前对人类造成最大损失的传染病是艾滋病毒。”
强大的抗病毒药物使人们能够与艾滋病毒感染者生活多年。但这种疾病继续破坏着许多低收入和中等收入国家,有95%的新的HIV感染在那里发生。世卫组织非洲区域内每25名成年人中就有近1名艾滋病毒呈阳性,占全世界艾滋病毒携带者的三分之二以上。
7.天花(Smallpox)

1980年,世界卫生大会宣布天花消失。但在此之前,人类与天花作斗争已有数千年的历史,该病杀死了约三分之一的感染者。它给幸存者留下了深深的永久性疤痕,并且常常失明。
在欧洲以外的地区死亡率很高,在游客将病毒带到其地区之前,人们与病毒的接触很少。例如,历史学家估计,美洲90%的土著人口死于欧洲探险家引入的天花。仅在20世纪,天花就杀死了3亿人。
Adalja博士说:“这不仅给死亡带来了沉重负担,而且也给失明的人造成诸多不便,这正是促使这场抗击运动从地球上消灭的原因。”
8.汉坦病毒(Hantavirus)

汉坦病毒可两种:引起汉坦病毒肺综合征(HPS),另一种引起汉坦病毒肾综合征出血热(HFRS)。前者主要流行于美国,在阿根廷、巴西、巴拉圭、玻利维亚以及德国也发现了病例。
主要临床表现为,在4日左右的发热、头痛等前驱期症状后,出现以非心源性肺水肿和高病死率(52.4%~78.0%)为特征的急性呼吸衰竭,重症3~7日死亡,生存者则很快恢复,无后遗症。其发病机制主要是病毒的直接致病作用,肾脏是早期原发性损伤器官,病毒是肾损伤的直接因素。
自20世纪80年代初成功分离病毒以来,HFRS和汉坦病毒的研究取得了大量成果,尤其近年来灭活疫苗的研制成功,为有效预防本病创造了条件。有些类型的疫苗已经国家批准生产使用,有的已进入临床观察中,有的正在试验室研制和检测中。
HPS于1993年在美国引起了广泛关注,当时一名随未婚妻生活在美国四角地区(Four Corners area亚利桑那州、科罗拉多州、新墨西哥州和犹他州)的纳瓦霍(Navajo印第安族群)健康青年男子在几天内死于呼吸急促。几个月后,卫生当局从一只感染者家中的鹿鼠(白足鼠)中分离出汉坦病毒。

美国四角地区

该病毒不会人际传播,主要受感染于小鼠的粪便。
根据《临床微生物学评论》(Clinical Microbiology Reviews)2010年的一篇论文,以前,另一种汉坦病毒于1950年代初在朝鲜战争期间爆发。3,000多名部队士兵被感染,其中约12%死亡。
虽然这种病毒在美国被发现时对西医来说很新,但研究人员后来意识到纳瓦霍人的医学传统描述了一种类似的疾病,才将这种疾病与小鼠联系起来。
9.流感(Influenza)

根据世卫组织数据,在典型的流感季节,全世界多达50万人将死于这种流行性疾病。但有时,当出现新的流感病毒株时,会导致大流行,疾病传播更快,死亡率通常更高。
最致命的流感大流行(有时也称为西班牙流感)始于1918年,使世界上多达40%的人口患病,造成5000万人死亡。
Muhlberger说:“我认为,像1918年流感爆发那样的事情有可能再次发生。” “如果一种新的流感毒株在人群中发现并且可以在人与人之间轻易传播并造成严重疾病,那么我们将面临一个大问题。”
10.登革热(Dengue)

登革热病毒最早出现于1950年代的菲律宾和泰国,此后已传播到全球热带和亚热带地区。现在,全球多达40%的人口生活在登革热流行的地区,随着全球气候变暖,这种疾病以及携带这种疾病的蚊子可能会传播得更远。

据世卫组织称,登革热每年使5000万至1亿人患病。尽管登革热的死亡率低于其他一些病毒,为2.5%,但该病毒可引起埃博拉样疾病,称为登革出血热,如果不加以治疗,死亡率能达到20%。
CDC称,美国食品药品监督管理局(FDA)于2019年批准了一种登革热疫苗,该疫苗可用于9-16岁居住在登革热常见地区且已证实有病毒感染史的儿童中。在某些国家/地区,适合9-45岁的儿童使用经过批准的疫苗,但同样,接受者必须过去曾确诊登革热。那些以前没有感染过这种病毒的人,如果接种了疫苗,可能会患上严重的登革热。
11.轮状病毒(Rotavirus)

轮状病毒是引起婴幼儿腹泻的主要病原体之一,其主要感染小肠上皮细胞,从而造成细胞损伤,引起腹泻。轮状病毒每年在夏秋冬季流行,感染途径为粪-口途径,临床表现为急性胃肠炎,呈渗透性腹泻病,病程一般为6-7天,发热持续1-2天,呕吐2~3天,腹泻5天,严重出现脱水症状。
现在有两种疫苗可以保护儿童免受轮状病毒感染,轮状病毒是引起婴幼儿严重腹泻病的主要原因。尽管发达国家的儿童很少死于轮状病毒感染,但该疾病是发展中国家的杀手。
12.SARS冠状病毒(SARS-CoV)

据世卫组织称,引起严重急性呼吸系统综合症或SARS的病毒于2002年首次出现在中国南方的广东省。该疾病引起发烧,发冷和身体疼痛,并经常发展为肺炎,这是一种严重的疾病,其中肺部发炎并充满脓液。SARS的估计死亡率为9.6%。但据CDC称,自2000年代初以来,没有新的SARS病例报告。
The 12 deadliest viruses on Earth
https://baike.baidu.com
大家都在看
-
10种植物“超级英雄”:耐辐射、吃重金属、能灭火,专治各种不服 你以为超级英雄只存在于漫画里?错!向日葵在切尔诺贝利吃核辐射,给大地“排毒”;一种沙漠苔藓能在火星存活,5000戈瑞辐射都照不死;桉树一把火烧光整片森林,只为给自己的种子清场……今天这10种植物的“超能力” ... 植物之最04-25
-
生活观察丨春游踏青,野菜野菌别乱采食 新华社昆明4月24日电 题:春游踏青,野菜野菌别乱采食新华社记者荆昭延“尝了几片见手青后,觉得头晕,然后就看见绿孔雀从厨房端了菜走出来,餐桌底下,又窜出来一只滇金丝猴,问我要不要再加点盐。”昆明市民江熠回 ... 植物之最04-25
-
梁朝伟谈出演《寂静的朋友》:与导演同频 与孤独共生 记者 曹玲娟由匈牙利导演伊尔蒂科·茵叶蒂编剧并执导,德国、匈牙利、法国、中国4国合拍的影片《寂静的朋友》于4月25日全国公映。在日前的上海发布会上,主演梁朝伟谈及这部与自己过往作品截然不同的电影时表示,接 ... 植物之最04-25
-
上新!川陕山地林下有新发现 被命名为大巴山假糙苏 封面新闻记者 戴竺芯4月24日,记者从四川省林草局获悉,由多所单位组成的研究团队在四川、陕西等地发现了一种未知的唇形科假糙苏属植物,被命名为大巴山假糙苏,相关研究成果近日发表于知名植物分类学期刊上。据介绍 ... 植物之最04-25
-
家里一定要养的5种国风绿植,自带东方禅意,瞬间拉满高级感 装修越简约,越靠绿植提气质。网红鲜花花期短、容易俗气,网红大叶绿植太过浮夸,唯有国风原生绿植,清雅、内敛、耐看、有底蕴。不用费心打理,不用重金入手,这5种经典国风植物,根植东方审美,摆进客厅、中堂、书 ... 植物之最04-25
-
养好金银花并不难,入手前注意看家里环境是否合适 金银花之所以会叫这个名字,就是因为它花蕾初开的时候是白色的,一两天之后,这个花蕾就会慢慢变成黄色,一颗植株上可以开出很多朵花,开花的时间不同,就能看到黄花和白花相互交映。故而得名金银花。上面是红白忍冬 ... 植物之最04-24
-
与导演同频 与孤独共生 《寂静的朋友》剧照。 资料图片由匈牙利导演伊尔蒂科·茵叶蒂编剧并执导,德国、匈牙利、法国、中国4国合拍的影片《寂静的朋友》于4月25日全国公映。在日前的上海发布会上,主演梁朝伟谈及这部与自己过往作品截然不 ... 植物之最04-24
-
厦门亿斯光年杨鑫玉:《植物学家》一部对前额叶十分友好的电影 刷完《植物学家》的第一个感受,不是“好看”或“不好看”,而是一种前所未有的松弛——没有烧脑反转,没有激烈冲突,甚至没有刻意煽情,就像坐在伊犁的山谷里,吹着风看草木生长,前额叶终于不用时刻紧绷,连呼吸都 ... 植物之最04-24
-
7岁就喜欢“躺平”!这株南非珍稀植物火了,还有2米多高上海最大巨蜜花,绝对让你大开眼界! 你或许还没去过南非但南非那些珍稀植物已空降黄浦南非巨蜜花、火炬花、刺花盏这些上海罕见的植物就在新天地的“南非花园”这片花园的主理人,是资深园艺博主、元述园艺工作室主理人柏淼。作为植物发烧友,他深耕园艺 ... 植物之最04-24
-
地球上最高的魔芋,在西双版纳开花了!花序高达2.5米 地球上最高大的魔芋——高魔芋开花了!这是近日在中国科学院西双版纳热带植物园发生的事情。高魔芋为天南星科魔芋属多年生草本植物,是世界上最高大的魔芋物种之一。原产于印度尼西亚苏门答腊岛热带雨林,对温湿度、 ... 植物之最04-24
相关文章
- 地球上最高的魔芋,在西双版纳开花了!花序高达2.5米
- 花青素之王就是它,隔天吃一次,延缓衰老,增强视力,增免疫
- 这5种花草美到窒息,你见过几种?
- 风中摇曳又静默如枝 ——谈《植物学家》中的自然诗学与存在美学
- 酢浆草:一株酢浆草,半点夏清凉
- 盘点《山海经》里的神奇植物,原来它们就藏在你身边!
- 世界上最痛的植物是???
- 别被它骗了!竹子是破坏力极强的植物,水泥、地基全挡不住
- “柔荑”不读róu yí,正确读音是什么?什么意思?和女人有关!
- 京城花问⑥丨“花王”牡丹“花相”芍药,你分得清二者吗?
- 上海的魅力在哪里?春天来看它……
- 五种植物很“疯狂”,养一棵就泛滥,看着美,种的人却左右为难
- 绳之万象从生存依托到文明脉络的千年进化
- 翻翻手机相册,4个季节的花草美到治愈
- 十大最漂亮的多肉植物,这10种多肉颜值爆表
- 照亮每一份成长!走进云南大山里的阳光驿站
- 花草不进无福之家;家里花草旺不旺,一眼就能看出你家有没有福气
- 别只养绿萝了!这5种绿植颜值吊打绿萝,还更好养,客厅秒变北欧风
- 复卦天机:植物破土那一刻,全靠18~28℃一阳来复
- 民间常说人养花、花亦养人,花草旺盛之家,日子大多和顺安稳
热门阅读
-
兰州烟价格表和图片 十款兰州烟经典款式价格 05-07
-
世界上十种最美的花:玫瑰花上榜,牡丹花居首 01-17
-
十大名贵君子兰排名:大花君子兰榜上有名 01-19
-
镇宅最吉利的三种花:桃花、君子兰位列前两名 04-17
-
多肉法师哪个品种最美?最美的多肉法师排行榜 04-17
-
10种植物的传播方式,种子的特点及传播途径 05-30
